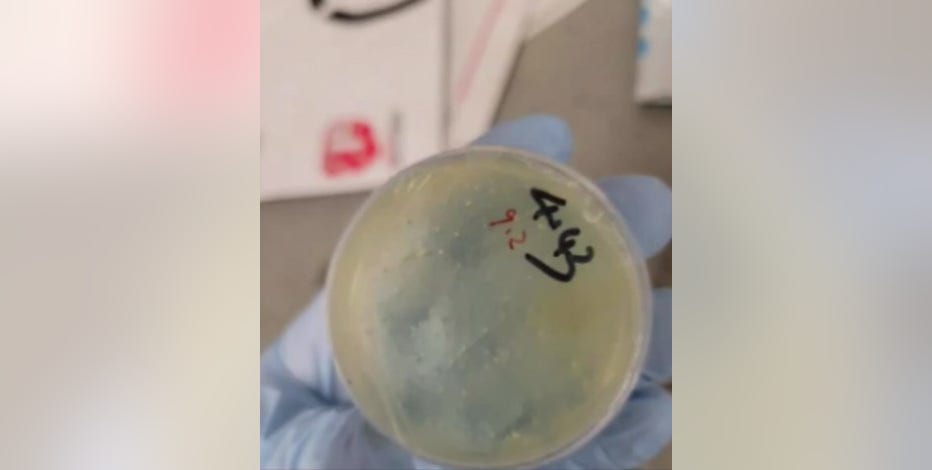
Second Chinese National charged with smuggling biological materials into US at Metro Airport

Chinese national linked to dangerous pathogen smuggling attempt at Detroit Metro due in court
Chinese national accused of smuggling due in court
A Chinese national accused of trying to smuggle a dangerous pathogen into the United States but was caught after her boyfriend was busted with the fungus at Detroit Metro Airport is due in court Friday for a detention hearing.
(FOX 2) - A Chinese national and researcher at the University of Michigan linked to an attempt to smuggle a dangerous pathogen into the United States is scheduled to appear in court Friday.
Yunqing Jian's detention hearing was postponed from last week because she was seeking a private attorney. She is facing charges of conspiracy, smuggling, and making false statements, and is currently in custody at the Sanilac County Jail.
The backstory:
The 33-year-old and her boyfriend, Zunyong Liu, 34, allegedly worked together to bring a fungus that damages wheat and other grains into the country.
Officials call it a potential agroterrorism threat.
"Agroterrorism, bioterrorism, is thankfully so rare, but, you know, requires constant vigilance to ensure that it stays rare," said Michael Singh, with the National Security Council.
According to the complaint, customs officials found the fungus stashed in the boyfriend's backpack as he was traveling through Detroit Metro Airport.
Liu told officials he wanted to conduct research on it at the University of Michigan, where his girlfriend worked. The university said in a statement that it is cooperating with authorities.
A deeper search revealed a document titled "2018 Plant-Pathogen Warfare Under Changing Climate Conditions" on the man's cellphone, according to authorities.
Customs officers denied him entry and sent him back to China.
A later search of his girlfriend's phone uncovered a form describing her membership in the Chinese Communist Party, authorities said.
The other side:
Some experts say it's still too early to call this a threat.
"Yes, this is a plant pathogen, but it's also one that is distributed globally," said Martin Chilvers, a Michigan State University professor. "The problem is that it could be a little bit different to what we already have here, and that's why it should have been brought in under regulated permits."
The Source: Previous FOX 2 stories were used in this report.